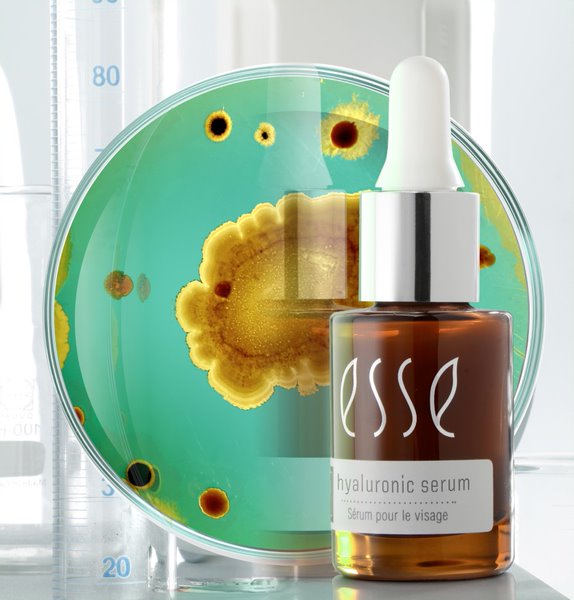
Hyaluronic Serum R6, 15ml

ESSE
ESSE Skincare ist eine südafrikanische Naturkosmetikmarke, die sich auf die Verwendung von Probiotika und präbiotischen Inhaltsstoffen konzentriert. Die Marke ist bekannt für ihre hochwertigen Produkte für das Gesicht und den Körper, die dazu beitragen, ein gesundes und ausgeglichenes Hautmikrobiom zu fördern.
- NEU
-
Marken
- Acca Kappa
- Alchimia
- Alga Maris
- Ancient + Brave
- Angel Minerals
- Annemarie Börlind
- Azur
- BalmYou
- Baybies Naturkosmetik
- Bastille
- Bioturm
- Bon Parfumeur
- Burts Bees
- Cocoon Botanicals
- Coeur de Beauté
- Dadosens
- Davinci Make-Up Tools
- Doers Of London
- Dr. Hauck
- Dr. Hauschka
- ESSE
- Farfalla
- Fine
- Florascent
- Frau Tonis Parfum
- Frosch
- Greenborn
- Havana Curls
- Ilia Beauty
- I + M
- INNERSENSE
- John Masters Organics
- Khadi
- Klar Seifen
- L'Erbolario
- La Crique
- LABRAINS
- L:A Bruket
- Lakshmi
- Leaf Shave
- Less Is More
- Lima
- Liv Interior
- Madara
- Maison Matine
- Manucurist
- Marie W
- Martina Gebhardt
- Max Benjamin
- Merme
- Midi12
- Munio
- Nailberry
- Neemen
- Noelie
- Oceanwell
- Ottoman
- Pharmos Natur
- Primavera
- Pure U
- Radico
- Redecker
- Studio Rundholz
- Salt & Stone
- SantaVerde
- Saponificio Varesino
- Savion
- Savon du Midi
- Sober Berlin
- Speick
- Stefano Ferrante Handtücher
- Steiner
- The Organic Pharmacy
- Torres Novas
- Twelve Beauty
- Und Gretel
- Urban Cosmetics Berlin
- Versatile
- Walde
- Weleda
- Whamisa
- Your Loving Nature
- ZEW for men
- Bijo;
- Copo Design
- J. F. Schwarzlose
- Looops
- beVIVID
- Lola's Apothecary
- Holistic Silk
- Inika
- Jaderoller
- Vujo Frischling
- Floris
- Rebels on Top
- Gesicht
- Make-Up
- Körper
- Haare
- Männer
- Lifestyle
- Duft
- Gutscheine
- Kosmetische Behandlungen

ESSE
ESSE Skincare ist eine südafrikanische Naturkosmetikmarke, die sich auf die Verwendung von Probiotika und präbiotischen Inhaltsstoffen konzentriert. Die Marke ist bekannt für ihre hochwertigen Produkte für das Gesicht und den Körper, die dazu beitragen, ein gesundes und ausgeglichenes Hautmikrobiom zu fördern.
Filter
–